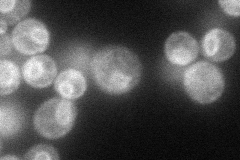
YFL001W
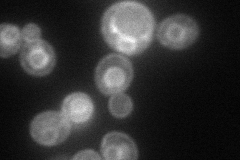
YFL001W
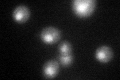
YFL001W

View description
tRNA:pseudouridine synthase, introduces pseudouridines at position 38 or 39 in tRNA, important for maintenance of translation efficiency and normal cell growth, localizes to both the nucleus and cytoplasm; non-essential for viability
Localization:
Intensity:
Fold change:
Significance:
-
C’ GFP library in SD

nucleus35.32 -
N' NOP1pr-GFP in SD
ER65.0837 -
N' TEF2pr-mCherry in SD
ER,vacuole73.6715 -
N' NATIVEpr-GFP in SD

punctate,ER23.9298 -
N' TEF2pr-VC and Cyto-VN in SD

#N/A0 -
C’ GFP library in SD+DTT
nucleus33.280.94No -
C’ GFP library in SD+H2O2

nucleus39.341.11No -
C’ GFP library in Starvation Media

nucleus20.30.57Yes -
C’ GFP library on the background of Pup2-DaMP

nucleus -
C’ GFP library on the background of CCT mutant

nucleus45.83891.29727No
